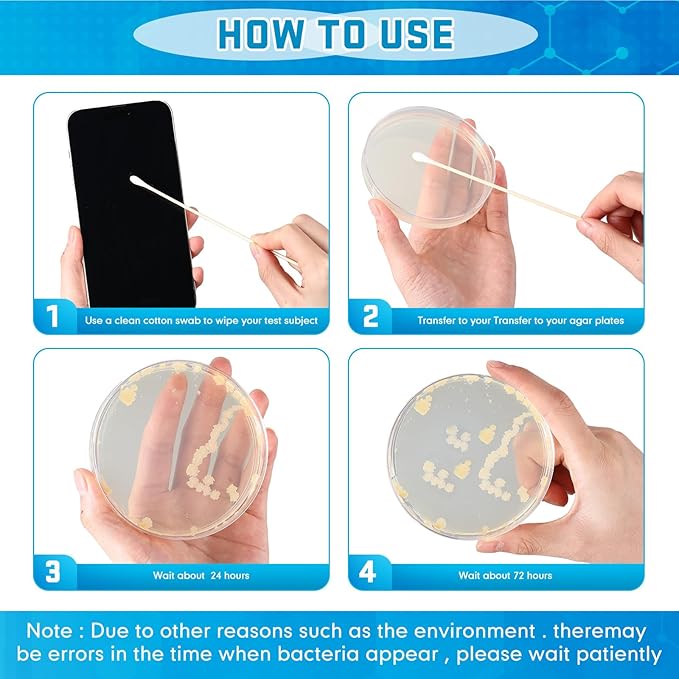

Relaxweex
90 Pieces Prepoured Agar Plates Kit Includes Petri Dishes with Agar Swabs Pipettes Storage Tubes Educational Science Kit Science Fair Project Kit to Learn Microbiology
90 Pieces Prepoured Agar Plates Kit Includes Petri Dishes with Agar Swabs Pipettes Storage Tubes Educational Science Kit Science Fair Project Kit to Learn Microbiology
Couldn't load pickup availability
About This
- Abundant Supplies: the prepoured agar plates kit includes 30 petri dishes, 30 cotton swabs, 15 pipettes 2 ml, and 15 storage tubes 5 ml, ensuring ample supplies for various experiments
- Durable and Quality Materials: the petri dish experiment kit is made of quality plastic material, ensuring safety and durability for lab use; Each petri dish contains a fresh and thick layer of agar; You can utilize these tools for conducting scientific experiments and fueling your curiosity towards science
- Safe and Convenient to Use: the materials of the agar dishes kit are safe and easy to handle; The petri dishes are designed with a tight fitting lid that avoids contamination and ensures that your experiments are safe and clean; The pipettes and storage tubes are easy to use and store, making your experiments simple
- Safe and Odorless: the petri dish agar kit is safe and odorless to use; This kit is also suitable for a wide range of science experiments, including microbiology, biology, chemistry, and more; It is ideal for home based experiments, classroom activities, and science fair projects
- Wide Use: the petri dish kit can be applied for a variety of science experiments such as observing the cellular processes of plants and animals, and other more settings; It is an essential tool for anyone interested in exploring the world of science
Share





Blog Posts
-

Tiny Moments, Big Meaning: How Nudii Baby Suppo...
In the whirlwind of modern parenting, it's easy to get caught up in the big milestones - the first steps, the first words, the first day of school. But what...
Tiny Moments, Big Meaning: How Nudii Baby Suppo...
In the whirlwind of modern parenting, it's easy to get caught up in the big milestones - the first steps, the first words, the first day of school. But what...
-

Softness, Safety, and Style: How Nudii Baby Cho...
As parents, we all want the best for our little ones. When it comes to dressing our babies, the choice of materials is paramount. At Nudii Baby, we understand this...
Softness, Safety, and Style: How Nudii Baby Cho...
As parents, we all want the best for our little ones. When it comes to dressing our babies, the choice of materials is paramount. At Nudii Baby, we understand this...
-

The Nudii Philosophy: Why Minimalism Matters in...
As a new parent, the endless stream of baby products and gear can feel overwhelming. Cribs, strollers, toys, and countless other items seem to multiply overnight, leaving many modern moms...
The Nudii Philosophy: Why Minimalism Matters in...
As a new parent, the endless stream of baby products and gear can feel overwhelming. Cribs, strollers, toys, and countless other items seem to multiply overnight, leaving many modern moms...
Customer Review
-
⭐️⭐️⭐️⭐️⭐️
The nursing pillow provides excellent support, making feeding time more comfortable for both baby and me. It’s soft yet firm enough to hold the baby safely.
William T.
-
⭐️⭐️⭐️⭐️⭐️
The sound machine helps my baby fall asleep faster and stay asleep longer. The variety of soothing sounds is wonderful, and it’s very easy to use.
Ella C.
-
⭐️⭐️⭐️⭐️⭐️
I love the bright colors and soft fabrics of these baby blankets. They are perfect for naps and playtime, keeping my baby cozy and comfortable.
Daniel M.
FAQ
How long does shipping take?
Shipping takes place within 3-5 business days. If there is a problem with the shipment of the product, we will notify you via the email address you entered when ordering.
Is free shipping available?
We do not currently offer free shipping. However, this may be added at some point. We apologize.
How can I get a tracking number for my order?
If your order has been shipped, we will add the tracking number to your order and notify you via the email address you entered when ordering.
How do I process a return or exchange?
For returns or exchanges, please contact us within 14 days of receiving the product, along with a receipt or screenshot of the purchase, and a photo of the product with the packaging or tag intact.